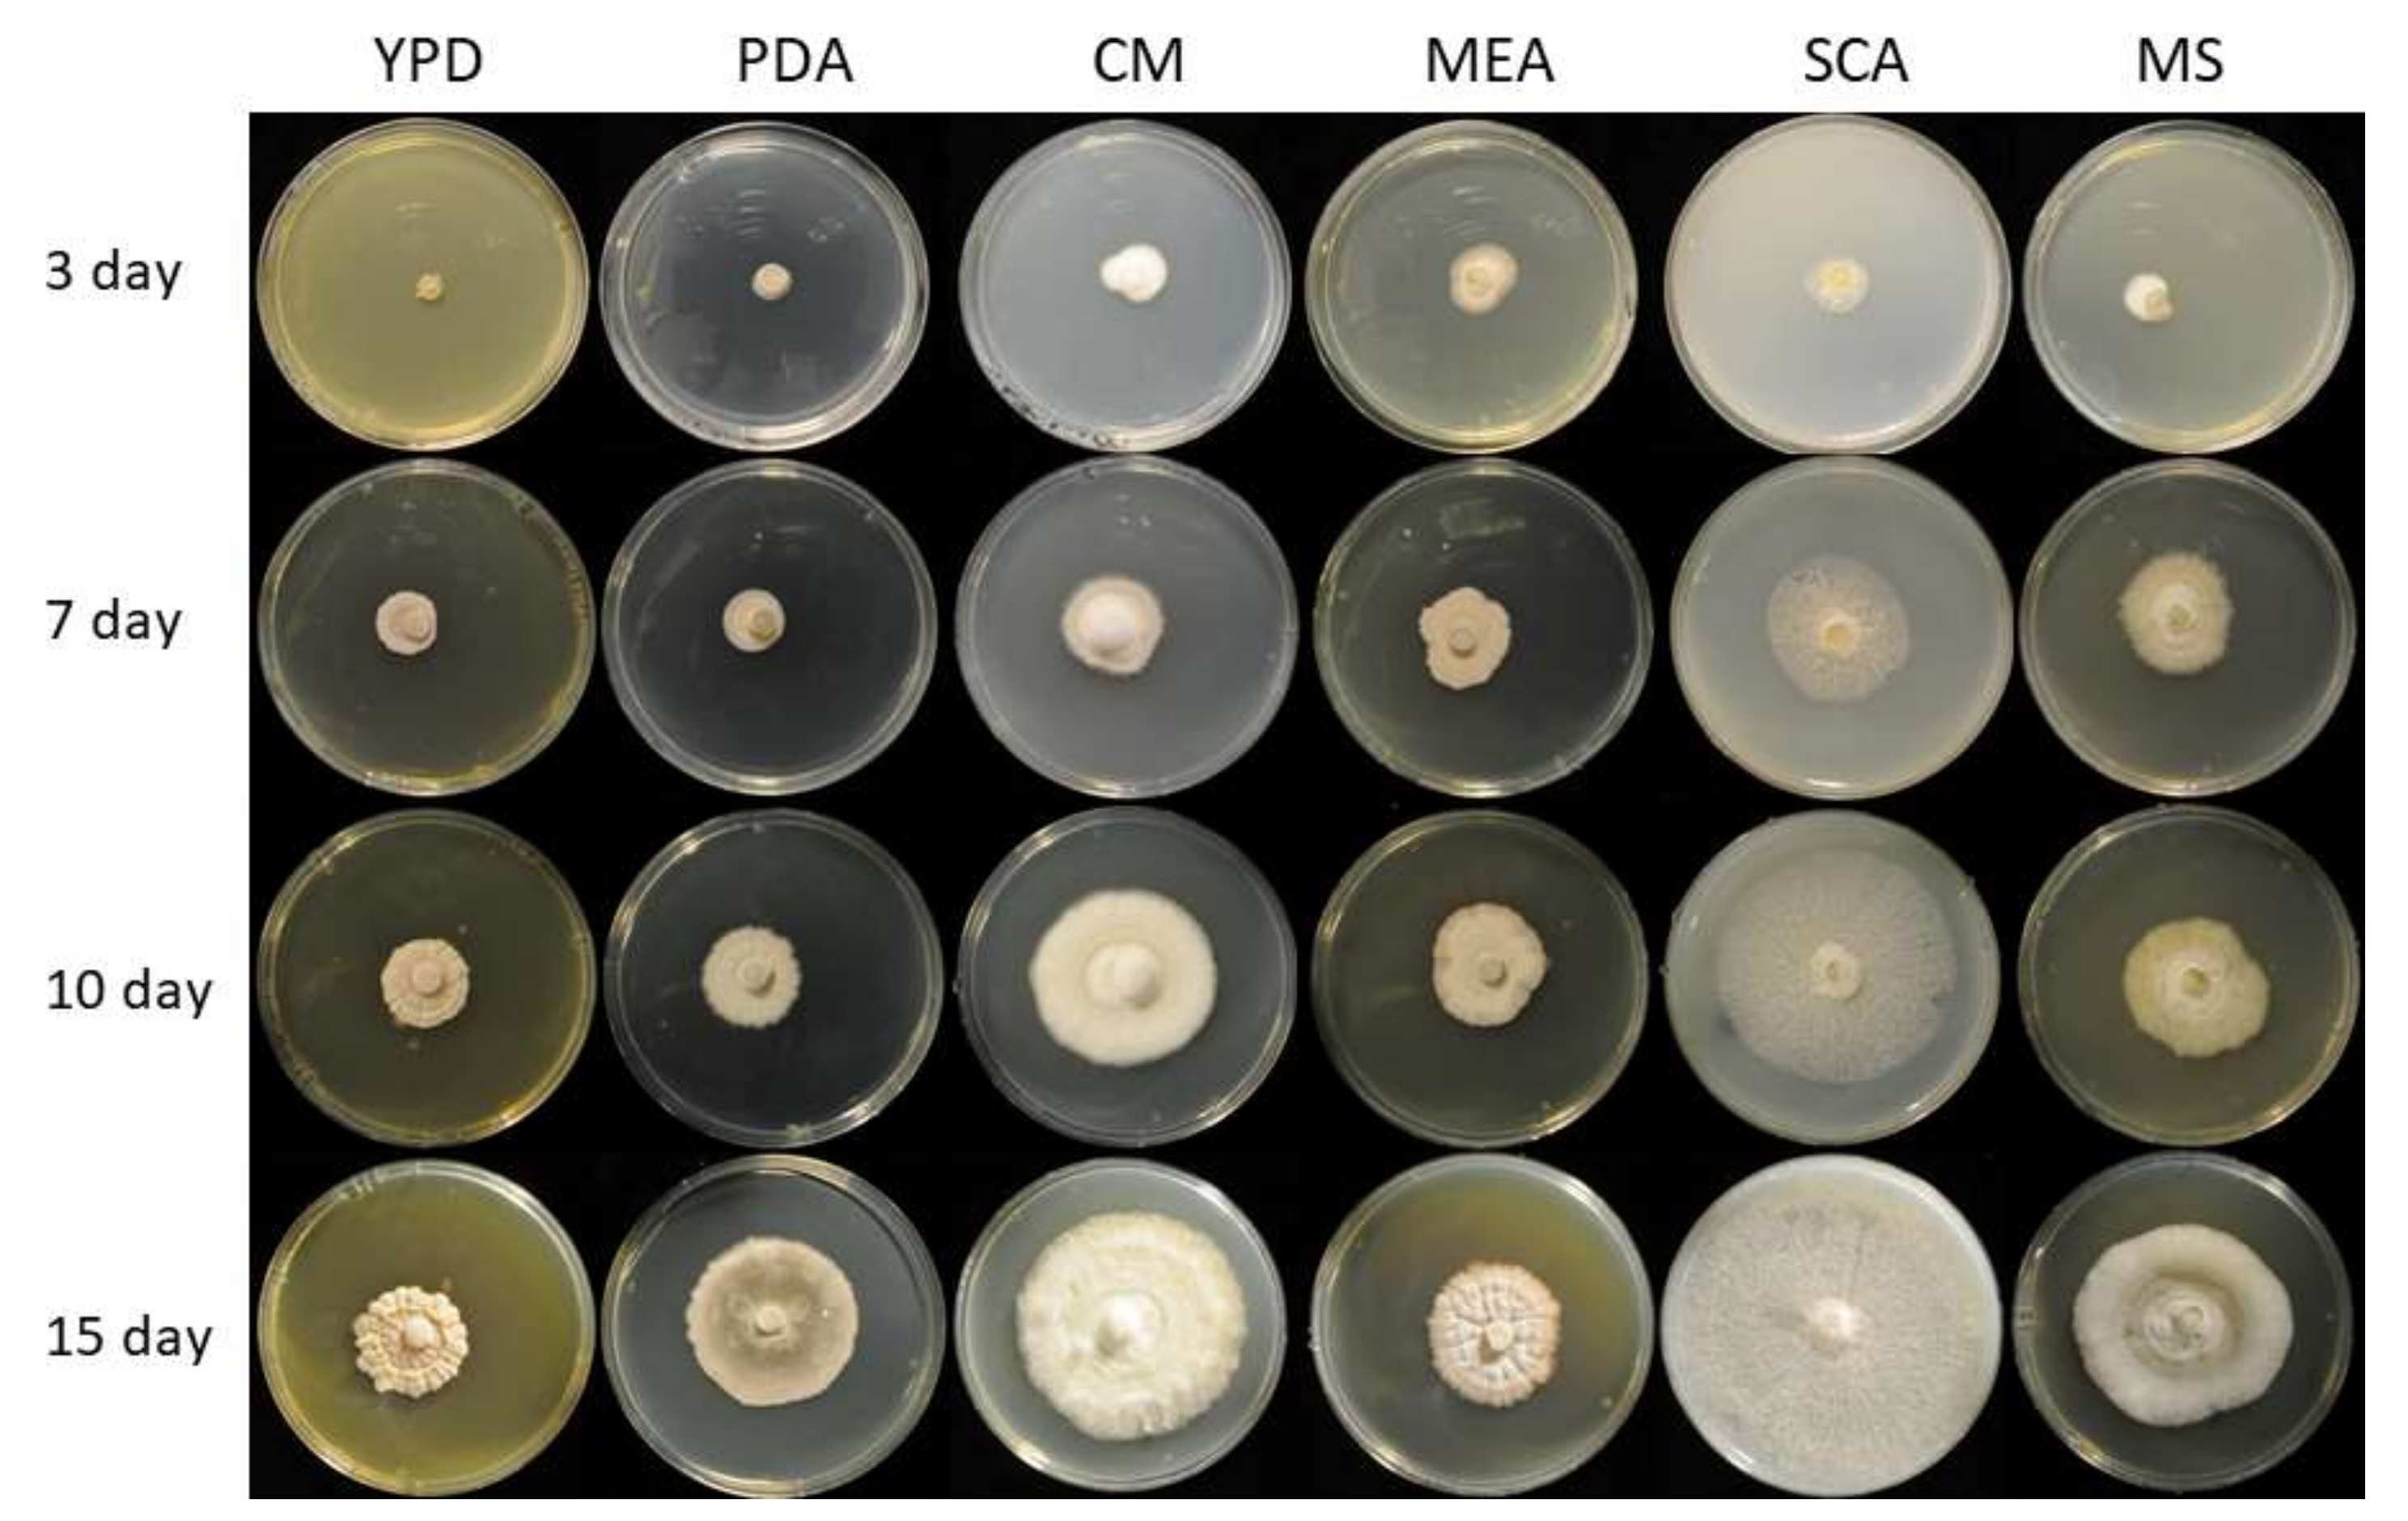
Microorganisms 09 01581 g001 Microorganisms 09 01581 g001

Genome and Secretome Analysis of Staphylotrichum longicolleum DSM105789 Cultured on Agro-Residual and Chitinous Biomass †
Abstract
1. Introduction
2. Materials and Methods
2.1. Fungus Isolation and Growth Conditions
2.2. Phylogenetic Analysis and De Novo Sequencing
2.3. Function Annotation and CAZyme Analysis
2.4. Secretome Analysis and SDS-PAGE
2.5. Proteomics
2.5.1. Sample Preparation
2.5.2. LC-MS/MS Analysis of the Secretomes
2.5.3. Protein Identification by Database Matching
2.6. Enzymatic Activity
2.7. Saccharification of Sugarcane Bagasse and Maize Leaves
3. Results
3.1. Genomic, Phylogenetic, and Growth Analysis of Staphylotrichum longicolleum FW57
3.2. CAZyme Analysis
3.3. Evaluation of Enzymatic Activity
3.4. Secretome Profiling of S. longicolleum FW57 on Chitinous and Agro-Residual Biomass
3.5. Conversion of Biomass with the In-House S. longicolleum FW57 Enzyme Mixture
4. Discussion
5. Conclusions
Supplementary Materials
Author Contributions
Funding
Institutional Review Board Statement
Informed Consent Statement
Data Availability Statement
Acknowledgments
Conflicts of Interest
References
- Serrano-Ruiz, J.C.; Luque, R.; Sepulveda-Escribano, A. Transformations of Biomass-Derived Platform Molecules: From high Added-Value Chemicals to Fuels via Aqueous-Phase Processing. Chem. Soc. Rev. 2011, 40, 5266–5281. [Google Scholar] [CrossRef]
- Hassan, S.S.; Williams, G.A.; Jaiswal, A.K. Lignocellulosic Biorefineries in Europe: Current State and Prospects. Trends Biotechnol. 2019, 37, 789. [Google Scholar] [CrossRef]
- Ahorsu, R.; Medina, F.; Constantí, M. Significance and Challenges of Biomass as a Suitable Feedstock for Bioenergy and Biochemical Production: A Review. Energies 2018, 11, 3366. [Google Scholar] [CrossRef]
- Leff, B.; Ramankutty, N.; Foley, J.A. Geographic Distribution of Major Crops Across the World. Glob. Biogeochem. Cy. 2004, 18. [Google Scholar] [CrossRef]
- Parent, B.; Leclere, M.; Lacube, S.; Semenov, M.A.; Welcker, C.; Martre, P.; Tardieu, F. Maize Yields Over Europe May Increase in Spite of Climate Change, with an Appropriate Use of the Genetic Variability of Flowering Time. PNAS 2018, 115, 10642–10647. [Google Scholar] [CrossRef]
- Jardine, A.; Sayed, S. Challenges in the valorisation of chitinous biomass within the biorefinery concept. Curr. Opin. Green Sustain. Chem. 2016, 2, 34–39. [Google Scholar] [CrossRef]
- Nascimento, M.S.; Santana, A.L.B.D.; Maranhão, C.A.; Oliveira, L.S.; Bieber, L. Phenolic Extractives and Natural Resistance of Wood; IntechOpen: London, UK, 2013. [Google Scholar]
- Gilbert, H.J. The Biochemistry and Structural Biology of Plant Cell Wall Deconstruction. Plant. Physiol. 2010, 153, 444–455. [Google Scholar] [CrossRef]
- Cantrell, S.A.; Dianese, J.C.; Fell, J.; Gunde-Cimerman, N.; Zalar, P. Unusual Fungal Niches. Mycologia 2011, 103, 1161–1174. [Google Scholar] [CrossRef]
- Chundawat, S.P.S.; Beckham, G.T.; Himmel, M.E.; Dale, B.E. Deconstruction of Lignocellulosic Biomass to Fuels and Chemicals. Annu Rev. Chem. Biomol. 2011, 2, 121–145. [Google Scholar] [CrossRef]
- Himmel, M.E.; Ding, S.Y.; Johnson, D.K.; Adney, W.S.; Nimlos, M.R.; Brady, J.W.; Foust, T.D. Biomass Recalcitrance: Engineering Plants and Enzymes for Biofuels Production. Science 2007, 315, 804–807. [Google Scholar] [CrossRef]
- Bajpai, P. Chapter 2-Xylan: Occurrence and Structure. In Xylanolytic Enzymes; Academic Press: Amsterdam, The Netherlands, 2014; pp. 9–18. [Google Scholar]
- Holtzapple, M.T. Hemicelluloses. In Encyclopedia of Food Sciences and Nutrition (Second Edition); Caballero, B., Finglas, P., Trugo, L., Eds.; Academic Press: Oxford, UK, 2003; pp. 3060–3071. [Google Scholar]
- York, W.S.; Vanhalbeek, H.; Darvill, A.G.; Albersheim, P. Structural Analysis of Xyloglucan Oligosaccharides by 1H-NNR Spectroscopy and Fast-Atom-Bombardment Mass-Spectrometry. Carbohyd Polym 1990, 200, 9–31. [Google Scholar] [CrossRef]
- Dos Santos, M.A.; Grenha, A. Chapter Seven—Polysaccharide Nanoparticles for Protein and Peptide Delivery: Exploring Less-Known Materials. In Advances in Protein Chemistry and Structural Biology; Donev, R., Ed.; Academic Press: Cambridge, MA, USA, 2015; Volume 98, pp. 223–261. [Google Scholar]
- Willför, S.; Sundberg, K.; Tenkanen, M.; Holmbom, B. Spruce-Derived Mannans—A Potential Raw Material for Hydrocolloids and Novel Advanced Natural Materials. Carbohyd. Polym. 2008, 72, 197–210. [Google Scholar] [CrossRef]
- Kashyap, D.R.; Vohra, P.K.; Chopra, S.; Tewari, R. Applications of Pectinases in the Commercial Sector: A Review. Bioresour. Technol. 2001, 77, 215–227. [Google Scholar] [CrossRef]
- Dekker, R.F.H. Biodegradation of the Hemicelluloses. In Biosynthesis and Biodegradation of Wood Components; Higuchi, T., Ed.; Academic Press: Cambridge, MA, USA, 1985; pp. 505–533. [Google Scholar]
- Bonnin, E.; Pelloux, J. Pectin Degrading Enzymes. In Pectin: Technological and Physiological Properties; Kontogiorgos, V., Ed.; Springer International Publishing: Cham, Switzerland, 2020; pp. 37–60. [Google Scholar]
- Chandel, A.K.; da Silva, S.S.; Singh, O.V. Detoxification of Lignocellulose Hydrolysates: Biochemical and Metabolic Engineering Toward White Biotechnology. Bioenerg. Res. 2013, 6, 388–401. [Google Scholar] [CrossRef]
- Foston, M.; Ragauskas, A. Biomass Characterization: Recent Progress in Understanding Biomass Recalcitrance. Ind. Biotechnol. 2012, 191–208. [Google Scholar] [CrossRef]
- Meng, X.Z.; Ragauskas, A.J. Recent Advances in Understanding the Role of Cellulose Accessibility in Enzymatic Hydrolysis of Lignocellulosic Substrates. Curr. Opin. Biotech. 2014, 27, 150–158. [Google Scholar] [CrossRef] [PubMed]
- Hosseini Koupaie, E.; Dahadha, S.; Bazyar Lakeh, A.A.; Azizi, A.; Elbeshbishy, E. Enzymatic pretreatment of lignocellulosic biomass for enhanced biomethane production-A review. J. Environ. Manage. 2019, 233, 774–784. [Google Scholar] [CrossRef]
- de Souza, A.P.; Leite, D.C.C.; Pattathil, S.; Hahn, M.G.; Buckeridge, M.S. Composition and Structure of Sugarcane Cell Wall Polysaccharides: Implications for Second-Generation Bioethanol Production. Bioenerg. Res. 2013, 6, 564–579. [Google Scholar] [CrossRef]
- Meineke, T.; Manisseri, C.; Voigt, C.A. Phylogeny in Defining Model Plants for Lignocellulosic Ethanol Production: A Comparative Study of Brachypodium distachyon, Wheat, Maize, and Miscanthus × giganteus Leaf and Stem Biomass. PLoS ONE 2014, 9. [Google Scholar] [CrossRef]
- Zeng, Y.N.; Himmel, M.E.; Ding, S.Y. Visualizing chemical functionality in plant cell walls. Biotechnol. Biofuels 2017, 10. [Google Scholar] [CrossRef]
- Eijsink, V.; Hoell, I.; Vaaje-Kolstada, G. Structure and function of enzymes acting on chitin and chitosan. Biotechnol. Genet. Eng. Rev. 2010, 27, 331–366. [Google Scholar] [CrossRef]
- Yadav, M.; Goswami, P.; Paritosh, K.; Kumar, M.; Pareek, N.; Vivekanand, V. Seafood waste: A source for preparation of commercially employable chitin/chitosan materials. Bioresour. Bioprocess. 2019, 6, 8. [Google Scholar] [CrossRef]
- Rinaudo, M. Chitin and chitosan: Properties and applications. Prog. Polym. Sci. 2006, 31, 603–632. [Google Scholar] [CrossRef]
- Yeul, V.S.; Rayalu, S.S. Unprecedented Chitin and Chitosan: A Chemical Overview. J. Polym. Environ. 2013, 21, 606–614. [Google Scholar] [CrossRef]
- Islam, S.; Bhuiyan, M.A.R.; Islam, M.N. Chitin and Chitosan: Structure, Properties and Applications in Biomedical Engineering. J. Polym. Environ. 2017, 25, 854–866. [Google Scholar] [CrossRef]
- Shamshina, J.L.; Berton, P.; Rogers, R.D. Chitin as a Resource for Eco-Friendly Bioplastics. In Encyclopedia of Ionic Liquids; Zhang, S., Ed.; Springer: Singapore, 2020; pp. 1–8. [Google Scholar]
- Sapkota, S.; Chou, S.-F. Electrospun Chitosan-based Fibers for Wound Healing Applications. J. Biomater. 2020, 4, 51–57. [Google Scholar] [PubMed]
- Eijsink, V.G.H.; Vaaje-Kolstad, G.; Vårum, K.M.; Horn, S.J. Towards new enzymes for biofuels: Lessons from chitinase research. Trends Biotechnol. 2008, 26, 228–235. [Google Scholar] [CrossRef] [PubMed]
- Lopes, A.M.; Ferreira, E.X.; Moreira, L.R.S. An Update on Enzymatic Cocktails for Lignocellulose Breakdown. J. Appl. Microbiol. 2018, 125, 632–645. [Google Scholar] [CrossRef]
- Mueller, G.M.; Bills, G.F. Introduction. In Biodiversity of Fungi; Academic Press: Burlington, MA, USA, 2004; pp. 1–4. [Google Scholar]
- Blackwell, M. The Fungi: 1, 2, 3... 5.1 Million Species? Am. J. Bot. 2011, 98, 426–438. [Google Scholar] [CrossRef] [PubMed]
- Kirk, P.M.; Cannon, P.F.; Minter, D.W.; Stalpers, J.A. Dictionary of the Fungi; CABI: Wallingford, UK, 2008; Volume 10. [Google Scholar]
- Wang, X.W.; Houbraken, J.; Groenewald, J.Z.; Meijer, M.; Andersen, B.; Nielsen, K.F.; Crous, P.W.; Samson, R.A. Diversity and taxonomy of Chaetomium and chaetomium-like fungi from indoor environments. Stud. Mycol. 2016, 84, 145–224. [Google Scholar] [CrossRef]
- Kunze, G.; Schmidt, J.C. Mykologische Hefte. 1817. Available online: https://www.gbif.org/ja/species/2569332 (accessed on 20 July 2021).
- Zámocký, M.; Tafer, H.; Chovanová, K.; Lopandic, K.; Kamlárová, A.; Obinger, C. Genome sequence of the filamentous soil fungus Chaetomium cochliodes reveals abundance of genes for heme enzymes from all peroxidase and catalase superfamilies. BMC Genom. 2016, 17. [Google Scholar] [CrossRef]
- Amlacher, S.; Sarges, P.; Flemming, D.; van Noort, V.; Kunze, R.; Devos, D.P.; Arumugam, M.; Bork, P.; Hurt, E. Insight into Structure and Assembly of the Nuclear Pore Complex by Utilizing the Genome of a Eukaryotic Thermophile. Cell 2011, 146, 277–289. [Google Scholar] [CrossRef] [PubMed]
- Cuomo, C.A.; Untereiner, W.A.; Ma, L.J.; Grabherr, M.; Birren, B.W. Draft Genome Sequence of the Cellulolytic Fungus Chaetomium globosum. Microbiol. Resour. Ann. 2015, 3. [Google Scholar] [CrossRef]
- Brandt, S.C.; Ellinger, B.; van Nguyen, T.; Thi, Q.D.; Van Nguyen, G.; Baschien, C.; Yurkov, A.; Hahnke, R.L.; Schäfer, W.; Gand, M. A unique fungal strain collection from vietnam characterized for high performance degraders of bioecological important biopolymers and lipids. PLoS ONE 2018, 13. [Google Scholar] [CrossRef] [PubMed]
- Wang, X.W.; Yang, F.Y.; Meijer, M.; Kraak, B.; Sun, B.D.; Jiang, Y.L.; Wu, Y.M.; Bai, F.Y.; Seifert, K.A.; Crous, P.W.; et al. Redefining Humicola sensu stricto and related genera in the Chaetomiaceae. Stud. Mycol. 2019, 65–153. [Google Scholar] [CrossRef] [PubMed]
- CSH Protocols. YPD media. Cold Spring Harb. Protoc. 2010, 2010, pdb.rec12315. [Google Scholar] [CrossRef]
- Leach, J.; Lang, B.R.; Yoder, O.C. Methods for Selection of Mutants and in vitro Culture of Cochliobolus heterostrophus. J. Gen. Microbiol. 1982, 128, 1719–1729. [Google Scholar] [CrossRef][Green Version]
- Raper, K.B.; Thom, C. A Manual of the Penicillia; Williams and Wilkons: Baltimore, MD, USA, 1949. [Google Scholar]
- Mohseni, M.; Norouzi, H.; Hamedi, J.; Roohi, A. Screening of Antibacterial Producing Actinomycetes from Sediments of the Caspian Sea. Int. J. Mol. Cell Med. 2013, 2, 64–71. [Google Scholar]
- Mandels, M.; Reese, E.T. Induction of Cellulase in Fungi by Cellobiose. J. Bacteriol. 1960, 79, 816–826. [Google Scholar] [CrossRef]
- Doyle, J.J.; Doyle, J.L. Isolation of Plant DNA From Fresh Tissue. Focus 1990, 12, 13–15. [Google Scholar]
- Richards, E.; Reichardt, M.; Rogers, S. Preparation of Genomic DNA From Plant Tissue. Curr. Protoc. Mol. Biol. 1994. Chapter 2. [Google Scholar] [CrossRef] [PubMed]
- White, T.J.; Bruns, T.; Lee, S.; Taylor, J. Amplification and Direct Sequencing of Fungal Ribosomal RNA Genes for Phylogenetics. In PCR Protocols: A Guide to Methods and Applications; Innis, M., Gelfand, D., Sninsky, J., White, T., Eds.; Academic Press: Orlando, FL, USA, 1990; pp. 315–322. [Google Scholar]
- Zhang, H.; Yohe, T.; Huang, L.; Entwistle, S.; Wu, P.Z.; Yang, Z.L.; Busk, P.K.; Xu, Y.; Yin, Y.B. dbCAN2: A Meta Server for Automated Carbohydrate-Active Enzyme Annotation. Nucleic Acids Res. 2018, 46, W95–W101. [Google Scholar] [CrossRef] [PubMed]
- Vogel, H.J. A convenient growth medium for Neurospora crassa. Microbiol. Genet. Bull. 1956, 13, 42–43. [Google Scholar]
- Rocha, G.J.M.; Gonçalves, A.R.; Oliveira, B.R.; Olivares, E.G.; Rossell, C.E.V. Steam Explosion Pretreatment Reproduction and Alkaline Delignification Reactions Performed on a Pilot Scale with Sugarcane Bagasse for Bioethanol Production. Ind. Crop. Prod. 2012, 35, 274–279. [Google Scholar] [CrossRef]
- Laemmli, U.K. Cleavage of Structural Proteins During the Assembly of the Head of Bacteriophage T4. Nature 1970, 227. [Google Scholar] [CrossRef]
- Shevchenko, A.; Tomas, H.; Havlis, J.; Olsen, J.V.; Mann, M. In-Gel Digestion for Mass Spectrometric Characterization of Proteins and Proteomes. Nat. Protoc. 2007, 1, 2856–2860. [Google Scholar] [CrossRef]
- Miller, G.L. Use of Dinitrosalicylic Acid Reagent for Determination of Reducing Sugar. Anal. Chem. 1959, 31. [Google Scholar] [CrossRef]
- Ghose, T.K. Measurement of Cellulase Activities. Pure Appl. Chem. 1987, 59, 257–268. [Google Scholar] [CrossRef]
- Zhang, Y.H.P.; Hong, J.; Ye, X. Cellulase Assays. Biofuels Methods Protoc. 2009, 213–231. [Google Scholar] [CrossRef]
- Ferrari, A.R.; Gaber, Y.; Fraaije, M.W. A fast, sensitive and easy colorimetric assay for chitinase and cellulase activity detection. Biotechnol. Biofuels 2014, 7. [Google Scholar] [CrossRef]
- Takeda, K.; Ishida, T.; Yoshida, M.; Samejima, M.; Ohno, H.; Igarashi, K.; Nakamura, N. Crystal Structure of the Catalytic and Cytochrome b Domains in a Eukaryotic Pyrroloquinoline Quinone-Dependent Dehydrogenase. Appl. Environ. Microbiol. 2019, 85. [Google Scholar] [CrossRef]
- Alvira, P.; Tomas-Pejo, E.; Ballesteros, M.; Negro, M.J. Pretreatment technologies for an efficient bioethanol production process based on enzymatic hydrolysis: A review. Bioresour. Technol. 2010, 101, 4851–4861. [Google Scholar] [CrossRef]
- Srivastava, N.; Rathour, R.; Jha, S.; Pandey, K.; Srivastava, M.; Thakur, V.K.; Sengar, R.S.; Gupta, V.K.; Mazumder, P.B.; Khan, A.F.; et al. Microbial Beta Glucosidase Enzymes: Recent Advances in Biomass Conversation for Biofuels Application. Biomolecules 2019, 9, 220. [Google Scholar] [CrossRef]
- Rohman, A.; Dijkstra, B.W.; Puspaningsih, N.N.T. β-Xylosidases: Structural Diversity, Catalytic Mechanism, and Inhibition by Monosaccharides. Int. J. Mol. Sci. 2019, 20, 5524. [Google Scholar] [CrossRef]
- Zheng, T.; Jiang, J.; Yao, J. Surfactant-promoted hydrolysis of lignocellulose for ethanol production. Fuel Process. Technol. 2021, 213, 106660. [Google Scholar] [CrossRef]
- Gruber, S.; Seidl-Seiboth, V. Self versus non-self: Fungal cell wall degradation in Trichoderma. Microbiology 2012, 158, 26–34. [Google Scholar] [CrossRef] [PubMed]
- Brurberg, M.B.; Eijsink, V.G.H.; Haandrikman, A.J.; Venema, G.; Nes, I.F. Chitinase B from Serratia marcescens BJL200 is exported to the periplasm without processing. Microbiology 1995, 141, 123–131. [Google Scholar] [CrossRef] [PubMed]
- Zakariassen, H.; Eijsink, V.G.H.; Sørlie, M. Signatures of activation parameters reveal substrate-dependent rate determining steps in polysaccharide turnover by a family 18 chitinase. Carbohydr. Polym. 2010, 81, 14–20. [Google Scholar] [CrossRef]
- Sørlie, M.; Horn, S.J.; Vaaje-Kolstad, G.; Eijsink, V.G.H. Using chitosan to understand chitinases and the role of processivity in the degradation of recalcitrant polysaccharides. React. Funct. Polym. 2020, 148, 104488. [Google Scholar] [CrossRef]
- Vaaje-Kolstad, G.; Horn, S.J.; Sørlie, M.; Eijsink, V.G.H. The chitinolytic machinery of Serratia marcescens – a model system for enzymatic degradation of recalcitrant polysaccharides. FEBS J. 2013, 280, 3028–3049. [Google Scholar] [CrossRef]
- Vázquez-Garcidueñas, S.; Leal-Morales, C.A.; Herrera-Estrella, A. Analysis of the beta-1,3-Glucanolytic System of the Biocontrol Agent Trichoderma harzianum. Appl. Environ. Microbiol. 1998, 64, 1442–1446. [Google Scholar] [CrossRef] [PubMed]
- Aragunde, H.; Biarnés, X.; Planas, A. Substrate Recognition and Specificity of Chitin Deacetylases and Related Family 4 Carbohydrate Esterases. Int. J. Mol. Sci. 2018, 19, 412. [Google Scholar] [CrossRef] [PubMed]
- Zhu, X.-F.; Tan, H.-Q.; Zhu, C.; Liao, L.; Zhang, X.-Q.; Wu, M. Cloning and overexpression of a new chitosanase gene from Penicillium sp. D-1. Amb Express 2012, 2, 13. [Google Scholar] [CrossRef]
- Bhatia, Y.; Mishra, S.; Bisaria, V.S. Microbial β-Glucosidases: Cloning, Properties, and Applications. Crit Rev. Biotechnol. 2002, 22, 375–407. [Google Scholar] [CrossRef] [PubMed]
- Singhania, R.R.; Patel, A.K.; Sukumaran, R.K.; Larroche, C.; Pandey, A. Role and Significance of β-Glucosidases in the Hydrolysis of Cellulose for Bioethanol Production. Bioresour. Technol. 2013, 127, 500–507. [Google Scholar] [CrossRef]
- Gao, J.; Wakarchuk, W. Characterization of Five β-Glycoside Hydrolases from Cellulomonas fimi ATCC 484. J. Bacteriol. 2014, 196, 4103–4110. [Google Scholar] [CrossRef] [PubMed]
- Glass, N.L.; Schmoll, M.; Cate, J.H.D.; Coradetti, S. Plant Cell Wall Deconstruction by Ascomycete Fungi. Annu Rev. Microbiol. 2013, 67, 477–498. [Google Scholar] [CrossRef] [PubMed]
- van den Brink, J.; de Vries, R.P. Fungal Enzyme Sets for Plant Polysaccharide Degradation. Appl. Microbiol. Biotechnol. 2011, 91, 1477–1492. [Google Scholar] [CrossRef]
- Poutanen, K.; Sundberg, M.; Korte, H.; Puls, J. Deacetylation of Xylans by Acetyl Esterases of Trichoderma reesei. Appl. Microbiol. Biot. 1990, 33, 506–510. [Google Scholar] [CrossRef]
- Saykhedkar, S.; Ray, A.; Ayoubi-Canaan, P.; Hartson, S.D.; Prade, R.; Mort, A.J. A Time Course Analysis of the Extracellular Proteome of Aspergillus nidulans Growing on Sorghum Stover. Biotechnol. Biofuels 2012, 5. [Google Scholar] [CrossRef]
- Hatfield, R.D.; Ralph, J.; Grabber, J.H. Cell wall cross-linking by ferulates and diferulates in grasses. J. Sci. Food Agric. 1999, 79, 403–407. [Google Scholar] [CrossRef]
- Collins, T.; Gerday, C.; Feller, G. Xylanases, xylanase families and extremophilic xylanases. FEMS Microbiol. Rev. 2005, 29, 3–23. [Google Scholar] [CrossRef] [PubMed]
- Zhao, Z.T.; Liu, H.Q.; Wang, C.F.; Xu, J.R. Comparative Analysis of Fungal Genomes Reveals Different Plant Cell Wall Degrading Capacity in Fungi. BMC Genome 2013, 14. [Google Scholar] [CrossRef] [PubMed]
- Borin, G.P.; Sanchez, C.C.; de Souza, A.P.; de Santana, E.S.; de Souza, A.T.; Leme, A.F.P.; Squina, F.M.; Buckeridge, M.; Goldman, G.H.; Oliveira, J.V.D. Comparative Secretome Analysis of Trichoderma reesei and Aspergillus niger during Growth on Sugarcane Biomass. PLoS ONE 2015, 10. [Google Scholar] [CrossRef] [PubMed]
- dos Santos, H.B.; Bezerra, T.M.S.; Pradella, J.G.C.; Delabona, P.; Lima, D.; Gomes, E.; Hartson, S.D.; Rogers, J.; Couger, B.; Prade, R. Myceliophthora thermophila M77 Utilizes Hydrolytic and Oxidative Mechanisms to Deconstruct Biomass. AMB Express 2016, 6. [Google Scholar] [CrossRef] [PubMed]
- Couturier, M.; Navarro, D.; Favel, A.; Haon, M.; Lechat, C.; Lesage-Meessen, L.; Chevret, D.; Lombard, V.; Henrissat, B.; Berrin, J.G. Fungal Secretomics of Ascomycete Fungi for Biotechnological Applications. Mycosphere 2016, 7, 1546–1553. [Google Scholar] [CrossRef]
- Brandt, S.C.; Brognaro, H.; Ali, A.; Ellinger, B.; Maibach, K.; Rühl, M.; Wrenger, C.; Schlüter, H.; Schäfer, W.; Betzel, C.; et al. Insights into the genome and secretome of Fusarium metavorans DSM105788 by cultivation on agro-residual biomass and synthetic nutrient sources. Biotechnol. Biofuels 2021, 14, 74. [Google Scholar] [CrossRef]
- Fernandez-Fueyo, E.; Ruiz-Dueñas, F.J.; Ferreira, P.; Floudas, D.; Hibbett, D.S.; Canessa, P.; Larrondo, L.F.; James, T.Y.; Seelenfreund, D.; Lobos, S.; et al. Comparative genomics of Ceriporiopsis subvermispora and Phanerochaete chrysosporium provide insight into selective ligninolysis. Proc. Natl. Acad. Sci. USA 2012, 109, 5458–5463. [Google Scholar] [CrossRef]
- Martinez, D.; Larrondo, L.F.; Putnam, N.; Gelpke, M.D.S.; Huang, K.; Chapman, J.; Helfenbein, K.G.; Ramaiya, P.; Detter, J.C.; Larimer, F.; et al. Genome sequence of the lignocellulose degrading fungus Phanerochaete chrysosporium strain RP78. Nat. Biotechnol. 2004, 22, 695–700. [Google Scholar] [CrossRef]
- Várnai, A.; Costa, T.H.F.; Faulds, C.B.; Milagres, A.M.F.; Siika-aho, M.; Ferraz, A. Effects of Enzymatic Removal of Plant Cell Wall Acylation (Acetylation, p-Coumaroylation, and Feruloylation) on Accessibility of Cellulose and Xylan in Natural (Non-Pretreated) Sugar Cane Fractions. Biotechnol. Biofuels 2014, 7. [Google Scholar] [CrossRef]
- Braga, C.M.P.; Delabona, P.D.; Lima, D.J.D.; Paixão, D.A.A.; Pradella, J.G.D.; Farinas, C.S. Addition of Feruloyl Esterase and Xylanase Produced on-site Improves Sugarcane Bagasse Hydrolysis. Bioresour. Technol. 2014, 170, 316–324. [Google Scholar] [CrossRef] [PubMed]
- Benoit, I.; Coutinho, P.M.; Schols, H.A.; Gerlach, J.P.; Henrissat, B.; de Vries, R.P. Degradation of Different Pectins by Fungi: Correlations and Contrasts Between the Pectinolytic Enzyme Sets Identified in Genomes and the Growth on Pectins of Different Origin. BMC Genome. 2012, 13. [Google Scholar] [CrossRef] [PubMed]
- Levasseur, A.; Drula, E.; Lombard, V.; Coutinho, P.M.; Henrissat, B. Expansion of the enzymatic repertoire of the CAZy database to integrate auxiliary redox enzymes. Biotechnol. Biofuels 2013, 6, 41. [Google Scholar] [CrossRef] [PubMed]
- Mathieu, Y.; Piumi, F.; Valli, R.; Aramburu, J.C.; Ferreira, P.; Faulds, C.B.; Record, E. Activities of Secreted Aryl Alcohol Quinone Oxidoreductases from Pycnoporus cinnabarinus Provide Insights into Fungal Degradation of Plant Biomass. Appl. Environ. Microbiol. 2016, 82, 2411–2423. [Google Scholar] [CrossRef] [PubMed]
- Vuong, T.V.; Foumani, M.; MacCormick, B.; Kwan, R.; Master, E.R. Direct Comparison of Glucooligosaccharide Oxidase Variants and Glucose Oxidase: Substrate Range and H2O2 Stability. Sci. Rep. 2016, 6. [Google Scholar] [CrossRef]
- Obruca, S.; Marova, I.; Matouskova, P.; Haronikova, A.; Lichnova, A. Production of Lignocellulose-Degrading Enzymes Employing Fusarium solani F-552. Folia. Microbiol. 2012, 57, 221–227. [Google Scholar] [CrossRef]
- Scully, E.D.; Hoover, K.; Carlson, J.; Tien, M.; Geib, S.M. Analysis of Fusarium solani Isolated from the Longhorned Beetle, Anoplophora glabripennis. PLoS ONE 2012, 7. [Google Scholar] [CrossRef]
- Bissaro, B.; Røhr, Å.K.; Müller, G.; Chylenski, P.; Skaugen, M.; Forsberg, Z.; Horn, S.J.; Vaaje-Kolstad, G.; Eijsink, V.G.H. Oxidative cleavage of polysaccharides by monocopper enzymes depends on H2O2. Nat. Chem. Biol. 2017, 13, 1123–1128. [Google Scholar] [CrossRef]
- Kracher, D.; Scheiblbrandner, S.; Felice, A.K.G.; Breslmayr, E.; Preims, M.; Ludwicka, K.; Haltrich, D.; Eijsink, V.G.H.; Ludwig, R. Extracellular electron transfer systems fuel cellulose oxidative degradation. Science 2016, 352, 1098–1101. [Google Scholar] [CrossRef]
- Berka, R.M.; Grigoriev, I.V.; Otillar, R.; Salamov, A.; Grimwood, J.; Reid, I.; Ishmael, N.; John, T.; Darmond, C.; Moisan, M.-C.; et al. Comparative genomic analysis of the thermophilic biomass-degrading fungi Myceliophthora thermophila and Thielavia terrestris. Nat. Biotechnol. 2011, 29, 922–927. [Google Scholar] [CrossRef]
- Bey, M.; Zhou, S.M.; Poidevin, L.; Henrissat, B.; Coutinho, P.M.; Berrin, J.G.; Sigoillot, J.C. Cello-Oligosaccharide Oxidation Reveals Differences between Two Lytic Polysaccharide Monooxygenases (Family GH61) from Podospora anserina. Appl. Environ. Microb. 2013, 79, 488–496. [Google Scholar] [CrossRef] [PubMed]
- Phillips, C.M.; Beeson, W.T.; Cate, J.H.; Marletta, M.A. Cellobiose dehydrogenase and a copper-dependent polysaccharide monooxygenase potentiate cellulose degradation by Neurospora crassa. ACS Chem. Biol. 2011, 6, 1399–1406. [Google Scholar] [CrossRef] [PubMed]
- Garajova, S.; Mathieu, Y.; Beccia, M.R.; Bennati-Granier, C.; Biaso, F.; Fanuel, M.; Ropartz, D.; Guigliarelli, B.; Record, E.; Rogniaux, H.; et al. Single-domain flavoenzymes trigger lytic polysaccharide monooxygenases for oxidative degradation of cellulose. Sci. Rep. 2016, 6, 28276. [Google Scholar] [CrossRef] [PubMed]
- Haddad Momeni, M.; Fredslund, F.; Bissaro, B.; Raji, O.; Vuong, T.V.; Meier, S.; Nielsen, T.S.; Lombard, V.; Guigliarelli, B.; Biaso, F.; et al. Discovery of fungal oligosaccharide-oxidising flavo-enzymes with previously unknown substrates, redox-activity profiles and interplay with LPMOs. Nat. Commun. 2021, 12, 2132. [Google Scholar] [CrossRef]
- Westereng, B.; Cannella, D.; Wittrup Agger, J.; Jørgensen, H.; Larsen Andersen, M.; Eijsink, V.G.H.; Felby, C. Enzymatic cellulose oxidation is linked to lignin by long-range electron transfer. Sci. Rep. 2015, 5, 18561. [Google Scholar] [CrossRef]
- Arantes, V.; Goodell, B. Current Understanding of Brown-Rot Fungal Biodegradation Mechanisms: A Review. In Deterioration and Protection of Sustainable Biomaterials; ACS Symposium Series; American Chemical Society: Washington, DC, USA, 2014; Volume 1158, pp. 3–21. [Google Scholar]
- Angelova, M.B.; Pashova, S.B.; Spasova, B.K.; Vassilev, S.V.; Slokoska, L.S. Oxidative stress response of filamentous fungi induced by hydrogen peroxide and paraquat. Mycol. Res. 2005, 109, 150–158. [Google Scholar] [CrossRef]
- Scott, B.R.; Huang, H.Z.; Frickman, J.; Halvorsen, R.; Johansen, K.S. Catalase improves saccharification of lignocellulose by reducing lytic polysaccharide monooxygenase-associated enzyme inactivation. Biotechnol. Lett. 2016, 38, 425–434. [Google Scholar] [CrossRef]
- Várnai, A.; Umezawa, K.; Yoshida, M.; Eijsink, V.G.H. The Pyrroloquinoline-Quinone-Dependent Pyranose Dehydrogenase from Coprinopsis cinerea Drives Lytic Polysaccharide Monooxygenase Action. Appl. Environ. Microbiol. 2018, 84, e00156-18. [Google Scholar] [CrossRef]
- Saloheimo, M.; Paloheimo, M.; Hakola, S.; Pere, J.; Swanson, B.; Nyyssönen, E.; Bhatia, A.; Ward, M.; Penttilä, M. Swollenin, a Trichoderma reesei protein with sequence similarity to the plant expansins, exhibits disruption activity on cellulosic materials. Eur. J. Biochem. 2002, 269, 4202–4211. [Google Scholar] [CrossRef]
- Anwar, Z.; Gulfraz, M.; Irshad, M. Agro-industrial Lignocellulosic Biomass a Key to Unlock the Future Bio-Energy: A Brief Review. J. Radiat. Res. Appl. Sci. 2014, 7, 163–173. [Google Scholar] [CrossRef]
- Sindhu, R.; Binod, P.; Pandey, A. Biological Pretreatment of Lignocellulosic Biomass—An Overview. Bioresour. Technol. 2016, 199, 76–82. [Google Scholar] [CrossRef] [PubMed]
- Sun, S.N.; Sun, S.L.; Cao, X.F.; Sun, R.C. The Role of Pretreatment in Improving the Enzymatic Hydrolysis of Lignocellulosic Materials. Bioresour. Technol. 2016, 199, 49–58. [Google Scholar] [CrossRef] [PubMed]
- Wang, K.; Chen, J.; Sun, S.-N.; Sun, R.-C. Chapter 6—Steam Explosion. In Pretreatment of Biomass; Pandey, A., Negi, S., Binod, P., Larroche, C., Eds.; Elsevier: Amsterdam, The Netherlands, 2015; pp. 75–104. [Google Scholar]
- Mikolasch, A.; Manda, K.; Schlüter, R.; Lalk, M.; Witt, S.; Seefeldt, S.; Hammer, E.; Schauer, F.; Jülich, W.-D.; Lindequist, U. Comparative analyses of laccase-catalyzed amination reactions for production of novel β-lactam antibiotics. Biotechnol. App. Biochem. 2012, 59, 295–306. [Google Scholar] [CrossRef] [PubMed]
- Schlüter, R.; Lippmann, R.; Hammer, E.; Gesell Salazar, M.; Schauer, F. Novel insights into the fungal oxidation of monoaromatic and biarylic environmental pollutants by characterization of two new ring cleavage enzymes. Appl. Microbiol. Biot. 2013, 97, 5043–5053. [Google Scholar] [CrossRef] [PubMed]
- Grunwald, P. Industrial Biocatalysis; Jenny Stanford Publishing: New York, NJ, USA, 2014; Volume 1. [Google Scholar]

| CAZyme Classes | Number of Detected Genes |
|---|---|
| Glycoside hydrolases (GHs) | 231 |
| GHs with carbohydrate-binding modules (CBMs) | 64 |
| GHs with CBMs with GHs | 1 |
| GHs with carbohydrate esterases (CEs) | 2 |
| GHs with glycosyl transferases (GTs) | 4 |
| CBMs | 11 |
| CEs | 47 |
| CEs with CBMs | 8 |
| Polysaccharide lyases (PLs) | 15 |
| PLs with CBMs | 0 |
| GTs | 95 |
| GTs with CBMs | 0 |
| GTs with auxiliary activities (AAs) | 1 |
| AAs | 108 |
| AAs with AAs | 2 |
| AAs with CBMs | 6 |
| AAs with AAs with CBMs | 1 |
Publisher’s Note: MDPI stays neutral with regard to jurisdictional claims in published maps and institutional affiliations. |
© 2021 by the authors. Licensee MDPI, Basel, Switzerland. This article is an open access article distributed under the terms and conditions of the Creative Commons Attribution (CC BY) license (https://creativecommons.org/licenses/by/4.0/).
Share and Cite
Ali, A.; Ellinger, B.; Brandt, S.C.; Betzel, C.; Rühl, M.; Wrenger, C.; Schlüter, H.; Schäfer, W.; Brognaro, H.; Gand, M. Genome and Secretome Analysis of Staphylotrichum longicolleum DSM105789 Cultured on Agro-Residual and Chitinous Biomass. Microorganisms 2021, 9, 1581. https://doi.org/10.3390/microorganisms9081581
Ali A, Ellinger B, Brandt SC, Betzel C, Rühl M, Wrenger C, Schlüter H, Schäfer W, Brognaro H, Gand M. Genome and Secretome Analysis of Staphylotrichum longicolleum DSM105789 Cultured on Agro-Residual and Chitinous Biomass. Microorganisms. 2021; 9(8):1581. https://doi.org/10.3390/microorganisms9081581
Chicago/Turabian StyleAli, Arslan, Bernhard Ellinger, Sophie C. Brandt, Christian Betzel, Martin Rühl, Carsten Wrenger, Hartmut Schlüter, Wilhelm Schäfer, Hévila Brognaro, and Martin Gand. 2021. "Genome and Secretome Analysis of Staphylotrichum longicolleum DSM105789 Cultured on Agro-Residual and Chitinous Biomass" Microorganisms 9, no. 8: 1581. https://doi.org/10.3390/microorganisms9081581
APA StyleAli, A., Ellinger, B., Brandt, S. C., Betzel, C., Rühl, M., Wrenger, C., Schlüter, H., Schäfer, W., Brognaro, H., & Gand, M. (2021). Genome and Secretome Analysis of Staphylotrichum longicolleum DSM105789 Cultured on Agro-Residual and Chitinous Biomass. Microorganisms, 9(8), 1581. https://doi.org/10.3390/microorganisms9081581

